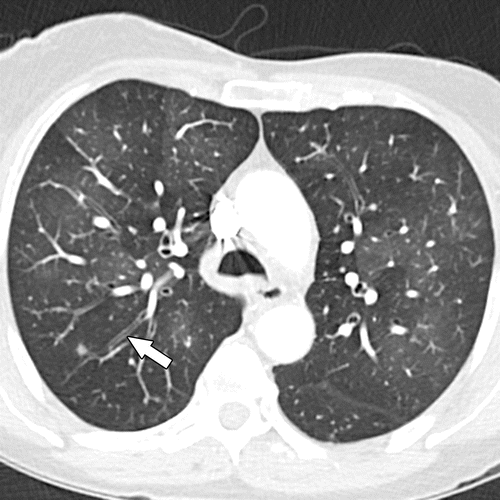

Bronquiolitis es una infección pulmonar que es muy común en niños pequeños y bebés. Regularmente suele causar inflamación y congestión de las pequeñas vías respiratorias es decir los bronquiolos del pulmón. Enfermedad es más común en los niños que los adultos.
Regularmente esta enfermedad la causa un virus y se suele presentar frecuentemente durante los meses de invierno. Si te interesa aprender más de esta enfermedad o crees que la puedes padecer sigue leyendo porque aquí te vamos a contar sobre sus síntomas y tratamientos comunes.
[Nextáge]
10Vacunas y tratamiento
Desafortunadamente, no hay vacunas para las causas más comunes de las bronquiolitis, sin embargo se recomienda una vacuna anual contra la gripe.
Las personas inmunodeprimidas que cursen una infección de bronquios, puede optar por usar palivizumab para disminuir la posibilidad de infecciones por este virus.
